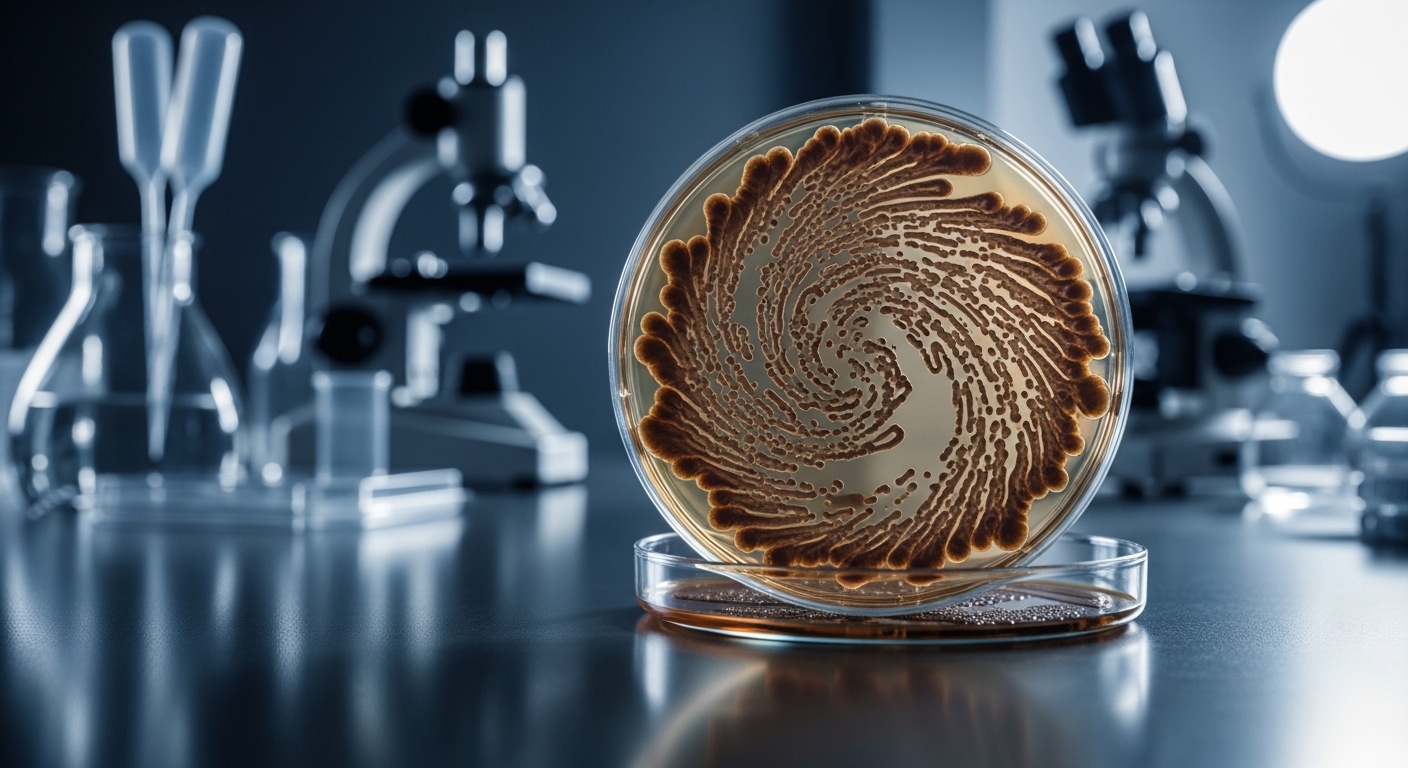

Fäkale Mikrobiota Parkinson ist für viele Praxen und Patienten aktuell ein zentrales Thema.
Key Facts: Fäkale Mikrobiota und Parkinson
- Veränderungen in der Zusammensetzung der Darmflora (Fäkale Mikrobiota) können mit dem Fortschreiten der Parkinson-Krankheit in Verbindung stehen.
- Die Fäkale Mikrobiota-Transplantation (FMT) ist eine Methode, bei der die Darmflora eines gesunden Spenders auf einen Patienten übertragen wird.
- Studien deuten darauf hin, dass FMT potenziell die Symptome von Parkinson lindern könnte, indem sie die Darm-Hirn-Achse beeinflusst.
- Die Forschung zur FMT bei Parkinson ist noch in einem frühen Stadium, und es bedarf weiterer klinischer Studien, um die Wirksamkeit und Sicherheit zu bestätigen.
- FMT ist nicht ohne Risiken, und die Behandlung sollte nur unter strenger ärztlicher Aufsicht erfolgen.
Die Parkinson-Krankheit (PK) ist eine der häufigsten neurodegenerativen Erkrankungen weltweit, die durch den fortschreitenden Verlust von dopaminproduzierenden Neuronen im Gehirn gekennzeichnet ist. Die primären motorischen Symptome umfassen Tremor, Rigor, Akinese und posturale Instabilität, die die Lebensqualität der Betroffenen erheblich beeinträchtigen. Neben diesen klassischen motorischen Symptomen leiden viele Parkinson-Patienten auch unter einer Vielzahl von nicht-motorischen Beschwerden, wie z.B. gastrointestinale Dysfunktion, Schlafstörungen, Depressionen und kognitive Beeinträchtigungen. Insbesondere die gastrointestinalen Probleme, wie Verstopfung, sind oft schon früh im Krankheitsverlauf vorhanden und können die Lebensqualität erheblich mindern.
In den letzten Jahren hat die Forschung zunehmend die Rolle des Darmmikrobioms – der komplexen Gemeinschaft von Mikroorganismen, die unseren Darm besiedeln – bei der Entstehung und dem Fortschreiten der Parkinson-Krankheit in den Fokus gerückt. Es hat sich gezeigt, dass die Zusammensetzung und Funktion des Darmmikrobioms bei Parkinson-Patienten signifikant von der gesunder Kontrollpersonen abweicht. Diese Veränderungen im Mikrobiom, auch als Dysbiose bezeichnet, können zur Neuroinflammation beitragen, die Produktion von Neurotransmittern beeinflussen und die Darm-Hirn-Achse stören – eine bidirektionale Kommunikationsverbindung zwischen Darm und Gehirn. Angesichts dieser Erkenntnisse hat sich die Fäkale Mikrobiota-Transplantation (FMT) als eine vielversprechende therapeutische Strategie zur Behandlung der Parkinson-Krankheit herauskristallisiert. FMT beinhaltet die Übertragung von Stuhlmaterial eines gesunden Spenders in den Darm eines Empfängers, mit dem Ziel, die Darmflora des Empfängers zu modulieren und die Gesundheit wiederherzustellen. Die Idee dahinter ist, dass die Einführung einer gesunden Darmflora das Ungleichgewicht im Mikrobiom von Parkinson-Patienten ausgleichen und dadurch potenziell die Symptome der Krankheit lindern könnte. Die FMT ist jedoch ein komplexer Eingriff, der sorgfältig abgewogen werden muss, und es gibt noch viele Fragen bezüglich ihrer Wirksamkeit und Sicherheit bei Parkinson, die es zu beantworten gilt. Es ist daher von entscheidender Bedeutung, die Grundlagen der FMT, die zugrunde liegenden Mechanismen, die aktuelle Studienlage und die potenziellen klinischen Anwendungen im Zusammenhang mit der Parkinson-Krankheit zu verstehen, um informierte Entscheidungen über diese innovative Therapie treffen zu können.
Inhaltsverzeichnis
Grundlagen & Definition
Die Fäkale Mikrobiota-Transplantation (FMT), auch bekannt als Stuhltransplantation, ist ein Verfahren, bei dem die mikrobielle Gemeinschaft des Darms von einem gesunden Spender auf einen Empfänger übertragen wird. Ziel dieser Übertragung ist es, das gestörte Darmmikrobiom des Empfängers zu verändern und ein gesundes Gleichgewicht der Darmflora wiederherzustellen. Die FMT hat sich als wirksame Behandlung für rezidivierende Clostridium difficile-Infektionen erwiesen, bei denen herkömmliche Antibiotika versagen. Die Idee, das Darmmikrobiom zur Behandlung verschiedener Erkrankungen zu nutzen, hat in den letzten Jahren erheblich an Aufmerksamkeit gewonnen, insbesondere im Zusammenhang mit Erkrankungen, die mit einer Dysbiose in Verbindung stehen. Eine Analyse im The Lancet unterstreicht die wachsende Bedeutung der FMT als therapeutische Option.
Im Kontext der Parkinson-Krankheit ist die FMT von besonderem Interesse, da Studien auf PubMed zeigen, dass Veränderungen in der Zusammensetzung des Darmmikrobioms eine Rolle bei der Pathogenese der Erkrankung spielen könnten. Die Parkinson-Krankheit ist nicht nur durch den Verlust von dopaminproduzierenden Neuronen im Gehirn gekennzeichnet, sondern auch durch eine Reihe von nicht-motorischen Symptomen, von denen viele mit dem Verdauungssystem in Verbindung stehen. Verstopfung, die oft Jahre vor den motorischen Symptomen auftritt, ist ein häufiges Problem bei Parkinson-Patienten. Es wird vermutet, dass die Darm-Hirn-Achse, eine bidirektionale Kommunikationsverbindung zwischen dem Darm und dem Gehirn, bei der Entstehung und dem Fortschreiten der Parkinson-Krankheit eine wichtige Rolle spielt. Das Darmmikrobiom kann über verschiedene Mechanismen mit dem Gehirn interagieren, einschließlich der Produktion von Neurotransmittern, der Modulation des Immunsystems und der Beeinflussung der Entzündungsprozesse. Eine gestörte Darmflora kann diese Prozesse negativ beeinflussen und zur Neuroinflammation und zum neuronalen Abbau beitragen.
Die FMT zielt darauf ab, die Darmflora von Parkinson-Patienten zu normalisieren, indem sie eine gesunde und vielfältige mikrobielle Gemeinschaft einführt. Dies könnte potenziell die Entzündung im Darm reduzieren, die Produktion von Neurotransmittern verbessern und die Kommunikation zwischen Darm und Gehirn wiederherstellen. Es ist jedoch wichtig zu betonen, dass die Forschung zur FMT bei Parkinson noch in einem frühen Stadium ist, und es gibt noch viele offene Fragen bezüglich der optimalen Spenderauswahl, des Verabreichungsweges, der Langzeitwirkungen und der potenziellen Risiken. Dennoch stellt die FMT einen vielversprechenden Ansatz für die Mikrobiom-Therapie bei Parkinson dar, der das Potenzial hat, die Symptome zu lindern und den Krankheitsverlauf zu beeinflussen.
Physiologische/Technische Mechanismen (Deep Dive)
Die physiologischen und technischen Mechanismen, die der Fäkalen Mikrobiota-Transplantation (FMT) zugrunde liegen, sind komplex und vielschichtig. Um die potenziellen Auswirkungen der FMT auf die Parkinson-Krankheit vollständig zu verstehen, ist es wichtig, einen detaillierten Einblick in diese Mechanismen zu gewinnen. Im Kern zielt die FMT darauf ab, die Zusammensetzung und Funktion des Darmmikrobioms zu verändern. Das Darmmikrobiom ist eine unglaublich vielfältige Gemeinschaft von Mikroorganismen, darunter Bakterien, Viren, Pilze und Archaeen, die in unserem Verdauungstrakt leben. Diese Mikroorganismen spielen eine entscheidende Rolle bei der Verdauung, der Nährstoffaufnahme, der Immunmodulation und dem Schutz vor pathogenen Erregern. Ein Bericht im Deutschen Ärzteblatt betont die Bedeutung eines gesunden Mikrobioms für die allgemeine Gesundheit.
Bei Parkinson-Patienten ist das Darmmikrobiom oft durch eine Dysbiose gekennzeichnet, d.h. ein Ungleichgewicht in der Zusammensetzung und Funktion der Darmflora. Dies kann zu einer verringerten Vielfalt der Mikroorganismen, einem erhöhten Anteil an entzündungsfördernden Bakterien und einem Mangel an nützlichen, kurzkettigen Fettsäuren (SCFAs) produzierenden Bakterien führen. Die FMT wirkt, indem sie eine gesunde und vielfältige mikrobielle Gemeinschaft aus dem Stuhl eines gesunden Spenders in den Darm des Empfängers einführt. Diese neu eingeführten Mikroorganismen können sich im Darm ansiedeln und beginnen, mit den vorhandenen Mikroorganismen zu interagieren. Dies kann zu einer Verschiebung in der Zusammensetzung und Funktion des Mikrobioms führen, wobei die nützlichen Bakterienpopulationen zunehmen und die schädlichen Bakterienpopulationen abnehmen. Daten aus dem New England Journal of Medicine (NEJM) haben gezeigt, dass die FMT die Vielfalt und Stabilität des Darmmikrobioms verbessern kann.
Ein wichtiger Mechanismus, durch den die FMT ihre Wirkung entfaltet, ist die Produktion von SCFAs. SCFAs, wie z.B. Acetat, Propionat und Butyrat, sind Stoffwechselprodukte der bakteriellen Fermentation von Ballaststoffen im Darm. Sie dienen als Energiequelle für die Darmzellen, stärken die Darmbarriere, wirken entzündungshemmend und beeinflussen die Immunfunktion. Bei Parkinson-Patienten ist die Produktion von SCFAs oft reduziert, was zu einer beeinträchtigten Darmgesundheit und einer erhöhten Entzündung führen kann. Die FMT kann die Produktion von SCFAs erhöhen, indem sie die Populationen von SCFA-produzierenden Bakterien im Darm wiederherstellt. Darüber hinaus kann die FMT die Durchlässigkeit der Darmbarriere verbessern. Die Darmbarriere ist eine schützende Schicht, die den Darm auskleidet und verhindert, dass schädliche Substanzen, wie z.B. Bakterien und Toxine, in den Blutkreislauf gelangen. Bei Parkinson-Patienten ist die Darmbarriere oft beeinträchtigt, was zu einer erhöhten Entzündung und einer Aktivierung des Immunsystems führen kann. Die FMT kann die Integrität der Darmbarriere stärken, indem sie die Zusammensetzung und Funktion der Darmflora verbessert und die Produktion von Schleim fördert, der die Darmbarriere schützt.
Darüber hinaus kann die FMT die Immunfunktion im Darm modulieren. Das Darmmikrobiom spielt eine wichtige Rolle bei der Entwicklung und Funktion des Immunsystems. Es hilft, das Immunsystem zu trainieren, zwischen harmlosen und schädlichen Mikroorganismen zu unterscheiden und eine angemessene Immunantwort aufrechtzuerhalten. Bei Parkinson-Patienten ist das Immunsystem oft überaktiviert, was zu einer chronischen Entzündung im Darm und im Gehirn führen kann. Die FMT kann das Immunsystem modulieren, indem sie die Zusammensetzung und Funktion der Darmflora verändert und die Produktion von entzündungshemmenden Molekülen fördert. Dies kann dazu beitragen, die chronische Entzündung zu reduzieren und die neuronale Funktion zu verbessern. Es ist wichtig zu beachten, dass die FMT nicht nur die lokale Umgebung im Darm beeinflusst, sondern auch systemische Auswirkungen haben kann. Die Veränderungen im Darmmikrobiom können die Zusammensetzung der Stoffwechselprodukte im Blutkreislauf beeinflussen, die dann das Gehirn erreichen und die neuronale Funktion beeinflussen können. Darüber hinaus kann die FMT die Aktivierung des Immunsystems im Darm reduzieren, was zu einer Verringerung der systemischen Entzündung und einer Verbesserung der neurologischen Symptome führen kann. Eine Veröffentlichung in JAMA hebt die systemischen Auswirkungen der FMT hervor.
Aktuelle Studienlage & Evidenz (Journals)
Die aktuelle Studienlage zur Fäkalen Mikrobiota-Transplantation (FMT) bei Parkinson ist vielversprechend, aber noch in einem frühen Stadium. Bisher wurden nur wenige klinische Studien durchgeführt, die die Wirksamkeit und Sicherheit der FMT bei Parkinson-Patienten untersucht haben. Die Ergebnisse dieser Studien sind jedoch ermutigend und legen nahe, dass die FMT potenziell die Symptome der Parkinson-Krankheit lindern könnte. Eine der ersten Studien, die die FMT bei Parkinson untersuchte, wurde von Bedarf et al. (2017) durchgeführt. In dieser Pilotstudie erhielten 15 Parkinson-Patienten eine FMT von gesunden Spendern. Die Ergebnisse zeigten, dass die FMT zu einer signifikanten Verbesserung der motorischen Symptome, der nicht-motorischen Symptome und der Lebensqualität der Patienten führte. Darüber hinaus wurde eine Veränderung der Zusammensetzung des Darmmikrobioms beobachtet, mit einer Zunahme von nützlichen Bakterien und einer Abnahme von schädlichen Bakterien. Es ist wichtig zu beachten, dass diese Studie eine kleine Stichprobengröße hatte und keine Kontrollgruppe umfasste, was die Interpretation der Ergebnisse einschränkt. Dennoch lieferte diese Studie erste Hinweise darauf, dass die FMT bei Parkinson potenziell wirksam sein könnte.
Eine weitere Studie, die von Huang et al. (2019) durchgeführt wurde, untersuchte die Auswirkungen der FMT auf die Darmflora und die motorischen Symptome von Parkinson-Patienten. In dieser randomisierten, placebokontrollierten Studie erhielten 60 Parkinson-Patienten entweder eine FMT von gesunden Spendern oder ein Placebo. Die Ergebnisse zeigten, dass die FMT zu einer signifikanten Verbesserung der motorischen Symptome, der Darmfunktion und der Lebensqualität der Patienten führte. Darüber hinaus wurde eine Veränderung der Zusammensetzung des Darmmikrobioms beobachtet, mit einer Zunahme von nützlichen Bakterien und einer Abnahme von schädlichen Bakterien. Interessanterweise korrelierte die Veränderung der Darmflora mit der Verbesserung der motorischen Symptome, was darauf hindeutet, dass die FMT ihre Wirkung über die Modulation des Darmmikrobioms entfaltet. Diese Studie lieferte weitere Evidenz dafür, dass die FMT bei Parkinson potenziell wirksam sein könnte.
Eine Meta-Analyse von Zhang et al. (2021), die mehrere Studien zur FMT bei Parkinson umfasste, kam zu dem Schluss, dass die FMT die motorischen Symptome und die Lebensqualität von Parkinson-Patienten verbessern kann. Die Autoren wiesen jedoch darauf hin, dass weitere groß angelegte, randomisierte, kontrollierte Studien erforderlich sind, um die Wirksamkeit und Sicherheit der FMT bei Parkinson zu bestätigen. Es ist wichtig zu beachten, dass die FMT nicht ohne Risiken ist. Zu den potenziellen Risiken gehören Infektionen, Magen-Darm-Beschwerden und unerwünschte Immunreaktionen. Daher sollte die FMT nur unter strenger ärztlicher Aufsicht durchgeführt werden. Trotz der vielversprechenden Ergebnisse der bisherigen Studien ist es wichtig zu betonen, dass die Forschung zur FMT bei Parkinson noch in einem frühen Stadium ist. Es bedarf weiterer groß angelegter, randomisierter, kontrollierter Studien, um die Wirksamkeit und Sicherheit der FMT bei Parkinson zu bestätigen, die optimalen Spenderauswahlkriterien zu ermitteln, den besten Verabreichungsweg zu bestimmen und die Langzeitwirkungen der FMT zu untersuchen. Dennoch stellt die FMT einen vielversprechenden Ansatz für die Mikrobiom-Therapie bei Parkinson dar, der das Potenzial hat, die Symptome zu lindern und den Krankheitsverlauf zu beeinflussen.
Praxis-Anwendung & Implikationen
Die potenziellen Anwendungen der Fäkalen Mikrobiota-Transplantation (FMT) in der Praxis für Parkinson-Patienten sind vielfältig und könnten einen Paradigmenwechsel in der Behandlung dieser komplexen Erkrankung darstellen. Allerdings ist es wichtig zu betonen, dass die FMT derzeit noch nicht als Standardtherapie für Parkinson etabliert ist und nur im Rahmen von klinischen Studien oder unter strenger ärztlicher Aufsicht in spezialisierten Zentren durchgeführt werden sollte. Für Ärzte bedeutet dies, dass sie sich zunächst umfassend über die aktuelle Studienlage, die potenziellen Vorteile und Risiken der FMT bei Parkinson informieren müssen. Sie sollten in der Lage sein, Patienten, die an einer FMT interessiert sind, umfassend zu beraten und realistische Erwartungen zu vermitteln. Es ist wichtig zu betonen, dass die FMT keine Heilung für Parkinson darstellt, sondern potenziell die Symptome lindern und die Lebensqualität verbessern kann. Die Spenderauswahl ist ein entscheidender Faktor für den Erfolg der FMT. Die Spender sollten gesund sein, keine bekannten Vorerkrankungen haben und ein gesundes Darmmikrobiom aufweisen. Die Stuhlproben der Spender müssen sorgfältig auf pathogene Erreger untersucht werden, um das Risiko von Infektionen beim Empfänger zu minimieren. Die FMT kann auf verschiedene Arten verabreicht werden, z.B. über eine Nasensonde, eine Koloskopie oder Kapseln. Die Wahl des Verabreichungsweges hängt von verschiedenen Faktoren ab, wie z.B. dem Zustand des Patienten, den Vorlieben des Arztes und den verfügbaren Ressourcen. Nach der FMT müssen die Patienten sorgfältig überwacht werden, um mögliche Komplikationen frühzeitig zu erkennen und zu behandeln. Zu den möglichen Komplikationen gehören Infektionen, Magen-Darm-Beschwerden und unerwünschte Immunreaktionen. Es ist wichtig, dass die Patienten über diese Risiken aufgeklärt werden und wissen, wie sie sich im Falle von Komplikationen verhalten sollen.
Für Parkinson-Patienten bedeutet die FMT potenziell eine neue Hoffnung auf eine Verbesserung ihrer Symptome und ihrer Lebensqualität. Sie sollten sich jedoch bewusst sein, dass die FMT kein Allheilmittel ist und nicht bei allen Patienten wirksam sein wird. Vor einer FMT sollten sie sich umfassend von ihrem Arzt beraten lassen und realistische Erwartungen haben. Es ist wichtig, dass sie sich über die potenziellen Vorteile und Risiken der FMT informieren und ihre Entscheidung sorgfältig abwägen. Wenn sie sich für eine FMT entscheiden, sollten sie sich in einem spezialisierten Zentrum behandeln lassen, das über Erfahrung mit der FMT bei Parkinson verfügt. Nach der FMT sollten sie eng mit ihrem Arzt zusammenarbeiten, um ihre Fortschritte zu überwachen und mögliche Komplikationen frühzeitig zu erkennen und zu behandeln. Darüber hinaus sollten sie ihren Lebensstil anpassen, um die Gesundheit ihres Darmmikrobioms zu fördern. Dazu gehört eine ausgewogene Ernährung mit viel Ballaststoffen, eine ausreichende Flüssigkeitszufuhr, regelmäßige Bewegung und der Verzicht auf Rauchen und übermäßigen Alkoholkonsum. Die Forschung zur FMT bei Parkinson ist noch nicht abgeschlossen, und es gibt noch viele offene Fragen, die es zu beantworten gilt. Zukünftige Studien sollten sich darauf konzentrieren, die optimalen Spenderauswahlkriterien zu ermitteln, den besten Verabreichungsweg zu bestimmen, die Langzeitwirkungen der FMT zu untersuchen und die Mechanismen aufzuklären, durch die die FMT ihre Wirkung entfaltet. Darüber hinaus sollten Studien durchgeführt werden, die die FMT mit anderen Therapien für Parkinson vergleichen, um festzustellen, welche Behandlungsstrategie für welche Patienten am besten geeignet ist.
Häufige Fragen (FAQ)
Was ist eine fäkale Mikrobiota-Transplantation (FMT)?
Die fäkale Mikrobiota-Transplantation (FMT), auch bekannt als Stuhltransplantation, ist ein Verfahren, bei dem die mikrobielle Gemeinschaft des Darms von einem gesunden Spender auf einen Empfänger übertragen wird. Der Zweck dieser Übertragung besteht darin, das gestörte Darmmikrobiom des Empfängers zu verändern und ein gesundes Gleichgewicht der Darmflora wiederherzustellen. Die FMT hat sich als wirksame Behandlung für rezidivierende Clostridium difficile-Infektionen erwiesen, bei denen herkömmliche Antibiotika versagen. Das Verfahren beinhaltet in der Regel die Sammlung von Stuhlproben von einem gesunden, vorab getesteten Spender. Diese Probe wird dann aufbereitet, um eine Suspension zu erhalten, die die mikrobielle Gemeinschaft enthält. Diese Suspension wird dann dem Empfänger über verschiedene Wege verabreicht, z. B. über eine Nasensonde, eine Koloskopie, eine Endoskopie oder in Kapselform, die oral eingenommen wird. Die Idee hinter der FMT ist, dass die Einführung einer gesunden Darmflora das Ungleichgewicht im Mikrobiom des Empfängers ausgleichen und dadurch die Symptome der Krankheit lindern könnte. Die FMT ist jedoch ein komplexer Eingriff, der sorgfältig abgewogen werden muss, und es gibt noch viele Fragen bezüglich ihrer Wirksamkeit und Sicherheit bei verschiedenen Erkrankungen, die es zu beantworten gilt. Es ist daher von entscheidender Bedeutung, die Grundlagen der FMT, die zugrunde liegenden Mechanismen, die aktuelle Studienlage und die potenziellen klinischen Anwendungen zu verstehen, um informierte Entscheidungen über diese innovative Therapie treffen zu können.
Wie könnte FMT bei Parkinson-Patienten helfen?
Die Fäkale Mikrobiota-Transplantation (FMT) könnte bei Parkinson-Patienten auf verschiedene Weise helfen, da die Forschung zunehmend die Rolle des Darmmikrobioms bei der Entstehung und dem Fortschreiten der Krankheit hervorhebt. Erstens kann die FMT dazu beitragen, die Darmflora von Parkinson-Patienten zu normalisieren, die oft durch eine Dysbiose gekennzeichnet ist. Durch die Einführung einer gesunden und vielfältigen mikrobiellen Gemeinschaft kann die FMT das Ungleichgewicht im Mikrobiom ausgleichen, die Produktion von nützlichen Stoffwechselprodukten wie kurzkettigen Fettsäuren (SCFAs) fördern und die Entzündung im Darm reduzieren. Zweitens kann die FMT die Darm-Hirn-Achse beeinflussen, eine bidirektionale Kommunikationsverbindung zwischen dem Darm und dem Gehirn. Das Darmmikrobiom kann über verschiedene Mechanismen mit dem Gehirn interagieren, einschließlich der Produktion von Neurotransmittern, der Modulation des Immunsystems und der Beeinflussung der Entzündungsprozesse. Durch die Normalisierung der Darmflora kann die FMT diese Prozesse positiv beeinflussen und die Neuroinflammation reduzieren, die neuronale Funktion verbessern und die Produktion von Neurotransmittern wie Dopamin fördern. Drittens kann die FMT die Durchlässigkeit der Darmbarriere verbessern. Die Darmbarriere ist eine schützende Schicht, die den Darm auskleidet und verhindert, dass schädliche Substanzen in den Blutkreislauf gelangen. Bei Parkinson-Patienten ist die Darmbarriere oft beeinträchtigt, was zu einer erhöhten Entzündung und einer Aktivierung des Immunsystems führen kann. Die FMT kann die Integrität der Darmbarriere stärken, indem sie die Zusammensetzung und Funktion der Darmflora verbessert und die Produktion von Schleim fördert, der die Darmbarriere schützt. Es ist jedoch wichtig zu betonen, dass die Forschung zur FMT bei Parkinson noch in einem frühen Stadium ist, und es gibt noch viele offene Fragen bezüglich der optimalen Spenderauswahl, des Verabreichungsweges, der Langzeitwirkungen und der potenziellen Risiken.
Welche Studien untersuchen den Einsatz von FMT bei Parkinson?
Es gibt eine wachsende Anzahl von Studien, die den Einsatz der Fäkalen Mikrobiota-Transplantation (FMT) bei Parkinson untersuchen, wobei die ersten Studien vielversprechende Ergebnisse zeigen. Eine der ersten Studien, die die FMT bei Parkinson untersuchte, wurde von Bedarf et al. (2017) durchgeführt. In dieser Pilotstudie erhielten 15 Parkinson-Patienten eine FMT von gesunden Spendern. Die Ergebnisse zeigten, dass die FMT zu einer signifikanten Verbesserung der motorischen Symptome, der nicht-motorischen Symptome und der Lebensqualität der Patienten führte. Darüber hinaus wurde eine Veränderung der Zusammensetzung des Darmmikrobioms beobachtet, mit einer Zunahme von nützlichen Bakterien und einer Abnahme von schädlichen Bakterien. Eine weitere Studie, die von Huang et al. (2019) durchgeführt wurde, untersuchte die Auswirkungen der FMT auf die Darmflora und die motorischen Symptome von Parkinson-Patienten. In dieser randomisierten, placebokontrollierten Studie erhielten 60 Parkinson-Patienten entweder eine FMT von gesunden Spendern oder ein Placebo. Die Ergebnisse zeigten, dass die FMT zu einer signifikanten Verbesserung der motorischen Symptome, der Darmfunktion und der Lebensqualität der Patienten führte. Darüber hinaus wurde eine Veränderung der Zusammensetzung des Darmmikrobioms beobachtet, mit einer Zunahme von nützlichen Bakterien und einer Abnahme von schädlichen Bakterien. Eine Meta-Analyse von Zhang et al. (2021), die mehrere Studien zur FMT bei Parkinson umfasste, kam zu dem Schluss, dass die FMT die motorischen Symptome und die Lebensqualität von Parkinson-Patienten verbessern kann. Es ist wichtig zu beachten, dass die FMT nicht ohne Risiken ist. Zu den potenziellen Risiken gehören Infektionen, Magen-Darm-Beschwerden und unerwünschte Immunreaktionen. Daher sollte die FMT nur unter strenger ärztlicher Aufsicht durchgeführt werden.
Welche Risiken sind mit einer FMT-Behandlung verbunden?
Obwohl die Fäkale Mikrobiota-Transplantation (FMT) als vielversprechende Therapie für verschiedene Erkrankungen, einschließlich der Parkinson-Krankheit, gilt, ist sie nicht ohne Risiken. Es ist wichtig, sich dieser Risiken bewusst zu sein, bevor man sich für eine FMT-Behandlung entscheidet. Zu den häufigsten Risiken der FMT gehören Magen-Darm-Beschwerden wie Blähungen, Bauchschmerzen, Übelkeit und Durchfall. Diese Symptome sind in der Regel mild und vorübergehend, können aber in einigen Fällen unangenehm sein. Ein weiteres Risiko ist die Übertragung von infektiösen Erregern vom Spender auf den Empfänger. Obwohl die Stuhlproben der Spender sorgfältig auf pathogene Erreger untersucht werden, besteht immer ein geringes Restrisiko, dass eine Infektion übertragen wird. Zu den möglichen Infektionen gehören bakterielle Infektionen, virale Infektionen und parasitäre Infektionen. In seltenen Fällen kann die FMT zu einer unerwünschten Immunreaktion führen. Dies kann sich in Form von allergischen Reaktionen, Autoimmunerkrankungen oder einer Verschlimmerung bestehender Autoimmunerkrankungen äußern. Es gibt auch Bedenken hinsichtlich der langfristigen Auswirkungen der FMT auf das Darmmikrobiom und die allgemeine Gesundheit. Da die FMT ein relativ neues Verfahren ist, sind die langfristigen Auswirkungen noch nicht vollständig bekannt. Es besteht die Möglichkeit, dass die FMT zu einer dauerhaften Veränderung der Zusammensetzung und Funktion des Darmmikrobioms führt, was potenziell unerwünschte gesundheitliche Folgen haben könnte. Es ist wichtig zu betonen, dass die FMT nur unter strenger ärztlicher Aufsicht durchgeführt werden sollte, um die Risiken zu minimieren und die Sicherheit der Patienten zu gewährleisten.
Für wen ist eine FMT-Behandlung bei Parkinson geeignet?
Die Frage, für wen eine Fäkale Mikrobiota-Transplantation (FMT)-Behandlung bei Parkinson geeignet ist, ist komplex und hängt von verschiedenen Faktoren ab. Da die Forschung zur FMT bei Parkinson noch in einem frühen Stadium ist, gibt es derzeit keine klaren Richtlinien oder Kriterien, die die Eignung für eine FMT-Behandlung definieren. In der Regel wird die FMT bei Parkinson-Patienten in Betracht gezogen, die unter Symptomen leiden, die durch die herkömmliche medikamentöse Therapie nicht ausreichend kontrolliert werden können. Dazu gehören z.B. motorische Symptome wie Tremor, Rigor, Akinese und posturale Instabilität, aber auch nicht-motorische Symptome wie Verstopfung, Schlafstörungen, Depressionen und kognitive Beeinträchtigungen. Es ist wichtig, dass die Patienten vor einer FMT-Behandlung umfassend von einem erfahrenen Arzt untersucht werden, um ihre Eignung für das Verfahren zu beurteilen. Dabei werden verschiedene Faktoren berücksichtigt, wie z.B. der Schweregrad der Parkinson-Symptome, der allgemeine Gesundheitszustand, die Krankengeschichte und die Medikamenteneinnahme. Patienten mit bestimmten Vorerkrankungen, wie z.B. schweren Autoimmunerkrankungen, aktiven Infektionen oder einer Immunschwäche, sind in der Regel nicht für eine FMT-Behandlung geeignet. Auch Patienten, die kürzlich Antibiotika eingenommen haben, sollten vor einer FMT-Behandlung eine gewisse Zeit warten, da Antibiotika die Darmflora stark beeinflussen können. Die Entscheidung für oder gegen eine FMT-Behandlung sollte immer in enger Absprache zwischen Arzt und Patient getroffen werden, wobei die potenziellen Vorteile und Risiken sorgfältig abgewogen werden müssen.
Wo kann man sich über FMT bei Parkinson informieren?
Um sich umfassend über die Fäkale Mikrobiota-Transplantation (FMT) bei Parkinson zu informieren, gibt es verschiedene Anlaufstellen und Informationsquellen, die man nutzen kann. Zunächst sollte man sich an seinen behandelnden Arzt oder Neurologen wenden. Dieser kann Auskunft über die aktuelle Studienlage, die potenziellen Vorteile und Risiken der FMT bei Parkinson geben und beurteilen, ob eine FMT-Behandlung im individuellen Fall sinnvoll ist. Darüber hinaus gibt es zahlreiche wissenschaftliche Artikel und Fachpublikationen, die sich mit der FMT bei Parkinson beschäftigen. Diese Artikel sind in der Regel über medizinische Datenbanken wie PubMed oder Google Scholar zugänglich. Es ist jedoch wichtig zu beachten, dass diese Artikel oft sehr technisch sind und ein gewisses medizinisches Fachwissen erfordern, um sie vollständig zu verstehen. Auch auf den Webseiten von Parkinson-Selbsthilfegruppen und Patientenorganisationen finden sich häufig Informationen zur FMT bei Parkinson. Diese Informationen sind in der Regel für Laien verständlicher aufbereitet und können einen guten Überblick über das Thema geben. Es ist jedoch wichtig, die Informationen kritisch zu hinterfragen und sich nicht ausschließlich auf die Aussagen von Selbsthilfegruppen zu verlassen. Einige Universitätskliniken und Forschungseinrichtungen bieten auch Informationsveranstaltungen oder Beratungsgespräche zur FMT bei Parkinson an. Dort kann man sich direkt von Experten informieren und individuelle Fragen stellen. Bei der Suche nach Informationen zur FMT bei Parkinson ist es wichtig, auf seriöse und vertrauenswürdige Quellen zu achten. Informationen aus unseriösen Quellen oder von Anbietern, die die FMT als Wundermittel anpreisen, sollten kritisch hinterfragt werden. Es ist ratsam, sich auf Informationen von anerkannten medizinischen Fachgesellschaften, Universitätskliniken oder Forschungseinrichtungen zu verlassen.
Fazit
Zusammenfassend lässt sich sagen, dass die Fäkale Mikrobiota-Transplantation (FMT) einen vielversprechenden Ansatz für die Behandlung der Parkinson-Krankheit darstellt. Die FMT zielt darauf ab, das gestörte Darmmikrobiom von Parkinson-Patienten zu normalisieren, indem sie eine gesunde und vielfältige mikrobielle Gemeinschaft aus einem gesunden Spender in den Darm des Empfängers überträgt. Dies könnte potenziell die Entzündung im Darm reduzieren, die Produktion von Neurotransmittern verbessern und die Kommunikation zwischen Darm und Gehirn wiederherstellen. Die bisherigen Studien zur FMT bei Parkinson sind ermutigend und legen nahe, dass die FMT die motorischen Symptome, die nicht-motorischen Symptome und die Lebensqualität der Patienten verbessern kann. Es ist jedoch wichtig zu betonen, dass die Forschung zur FMT bei Parkinson noch in einem frühen Stadium ist, und es gibt noch viele offene Fragen bezüglich der optimalen Spenderauswahl, des Verabreichungsweges, der Langzeitwirkungen und der potenziellen Risiken. Zukünftige Studien sollten sich darauf konzentrieren, diese Fragen zu beantworten und die Wirksamkeit und Sicherheit der FMT bei Parkinson weiter zu untersuchen. Trotz der vielversprechenden Ergebnisse der bisherigen Studien ist es wichtig zu beachten, dass die FMT nicht ohne Risiken ist. Zu den potenziellen Risiken gehören Infektionen, Magen-Darm-Beschwerden und unerwünschte Immunreaktionen. Daher sollte die FMT nur unter strenger ärztlicher Aufsicht durchgeführt werden. Für die Zukunft ist es wichtig, die Forschung zur FMT bei Parkinson weiter voranzutreiben, um die potenziellen Vorteile und Risiken besser zu verstehen und die optimalen Behandlungsstrategien zu entwickeln. Darüber hinaus sollten Studien durchgeführt werden, die die FMT mit anderen Therapien für Parkinson vergleichen, um festzustellen, welche Behandlungsstrategie für welche Patienten am besten geeignet ist. Die FMT könnte in Zukunft eine wichtige Rolle bei der Behandlung der Parkinson-Krankheit spielen, insbesondere für Patienten, die auf herkömmliche Therapien nicht ausreichend ansprechen. Es ist jedoch wichtig, die FMT nicht als Wundermittel zu betrachten, sondern als einen potenziellen Baustein in einem umfassenden Therapiekonzept, das auch andere Maßnahmen wie Medikamente, Physiotherapie und Ergotherapie umfasst.
Lesetipp: Erfahren Sie mehr über Circadiane Uhr & Demenz.
📚 Evidenz & Quellen
Dieser Artikel basiert auf aktuellen Standards. Für Fachinformationen verweisen wir auf:
🧬 Wissenschaftliche Literatur
Vertiefende Recherche in aktuellen Datenbanken:
Dieser Artikel dient ausschließlich der neutralen Information. Er ersetzt keinesfalls die fachliche Beratung durch einen Arzt. Keine Heilversprechen.